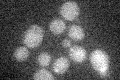
YOL022C
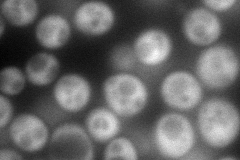
YOL022C
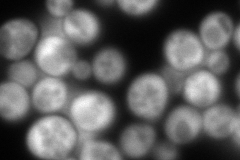
YOL022C
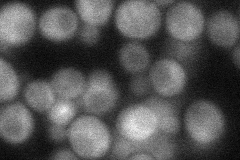
YOL022C
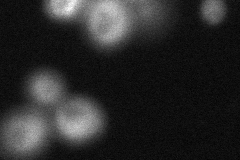
YOL022C

View description
Cytoplasmic protein of unknown function; essential gene in S288C background, while tsr4 null mutations in a CEN.PK2 background confer a reduced growth rate
Localization:
Intensity:
Fold change:
Significance:
-
C’ GFP library in SD
below threshold16.96 -
N' NOP1pr-GFP in SD
cytosol166.167 -
N' TEF2pr-mCherry in SD
cytosol326.222 -
N' NATIVEpr-GFP in SD
cytosol42.5802 -
N' TEF2pr-VC and Cyto-VN in SD
cytosol68.8712 -
C’ GFP library in SD+DTT

cytosol16.430.96No -
C’ GFP library in SD+H2O2

cytosol16.890.99No -
C’ GFP library in Starvation Media

cytosol13.140.77No -
C’ GFP library on the background of Pup2-DaMP

below threshold -
C’ GFP library on the background of CCT mutant

below threshold17.14031.00987No
